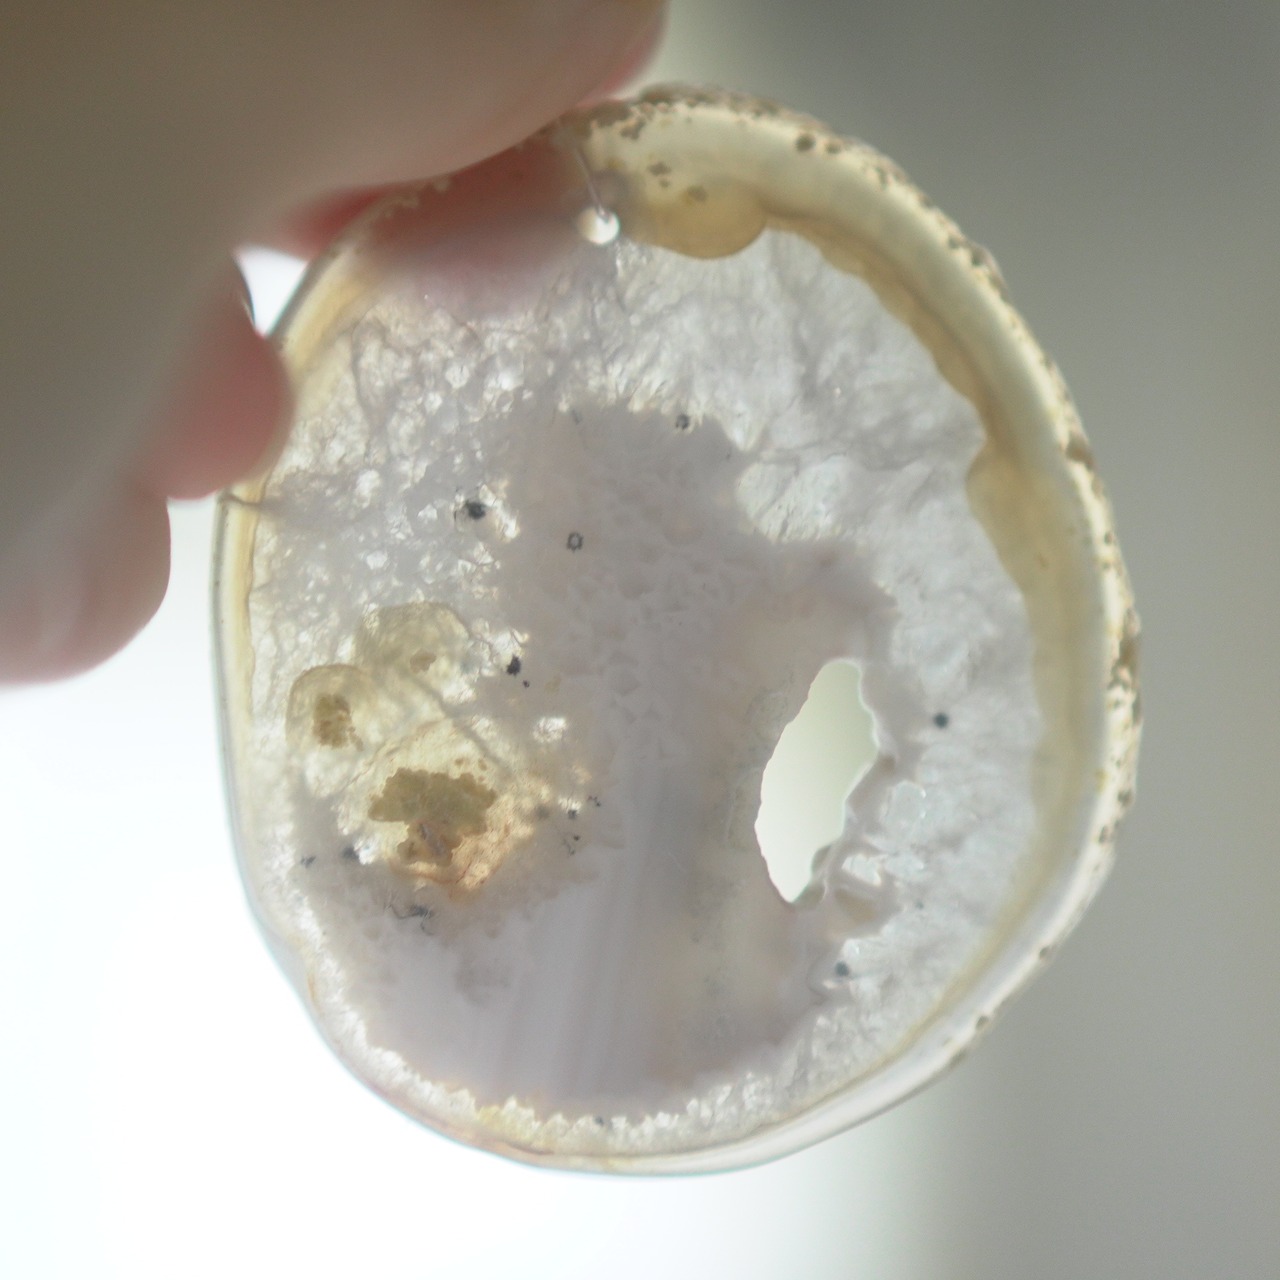
Crystal Moon 02 - アゲートヒーリングチャイム / Agate Sun Catcher Wind Chime 641

Crystal Moon 02 - アゲートヒーリングチャイム / Agate Sun Catcher Wind Chime 641
アゲートのヒーリングチャイムです。
透きとおる月をイメージした5連
ナチュラルカラーが美しい組み合わせです。
♬音色試聴動画はこちら↓(同じウィンドウのままYouTubeに飛びますので戻るボタンでお戻り下さい)
https://youtube.com/shorts/Jw1dd61M16I?si=UkH3Cw60yndipJ7e
【LENGTH】
63cm
メノウひとつあたりの長さおよそ6~8cm
(※リピート購入のお客様、もしも前回ご購入分と長さをできるだけ揃えられたい場合、長さは無料で調整できます。ご希望の場合はインスタのDMかHPのお問い合わせフォームにご購入の当日中にご連絡くださいませ◎^^)
【MATERIAL】
Agate Slice , Natural Wood , Nylon Cord , Metal
色柄や音色が美しく、空間浄化やサンキャッチャーにもなる瑪瑙のチャイム。
とても素敵なのですが国内で販売しているところをほとんど見かけず、
必要な人のところに届けばいいなという思いから素材から輸入し製作しています。
✧✧✧瑪瑙の濃い色は染色によるもので、水に濡れたり布で擦ると多少色落ちします。飾るものなので大丈夫かと思いますが白いお洋服などには触れないようにされてください。汚れが気になる時は若干の色落ち前提で水を軽く含ませた布やティッシュでやさしく拭いていただくことは大丈夫です。また、画像のような細かなヒビ・カケはスライスメノウの加工上かなり多くあるので、チャイムとしての機能や全体の外観を著しく損なうものを除き、見た目の完璧さ<音色の響き重視で選んで使用しております、よろしくお願い致します✧✧✧
連なるアゲートが風を受けて揺れるとチリンチリン、美しい響きの音が鳴りとても癒されます。
一点一点響きも異なりますが、音色も拘って製作しています。
ウィンドチャイムですが、一枚一枚出方の異なるアゲートの個性的な柄は吊るすだけでおしゃれなインテリアにもなりますので、季節問わずおすすめのアイテムです。
また、透明感が魅力でもあるので、窓際で自然光を通した際と、室内灯の下で光を通さずに見る際、異なる表情を見せてくれますのでその違いも是非お楽しみください。
そしてカーテン越しではなく直射日光を当てた際のサンキャッチャーとしてのチャイムも、美しい光をお部屋の中に運んでくれます。
※ブラウザ版ではこのページの下部に動画あり。
✧✧✧染色の石なので耐光性(光による経年でのカラー変化の耐性)に優れているわけではなく一日の中で長時間強い日光に当たるような場所に飾られるのはおすすめしないのですが、陽光に透かした時にだけ真価を発揮する美しさがありますので、是非たまに翳したりして光と一緒にお楽しみいただけたらと思っております。特に濃い鮮やかな色など、気になられる場合は、日光のあまり当たらない場所に飾っていただけたらと思います✧✧✧
天然の素材&手作業のものですので一点一点長さなども異なり、また、
メノウは同じ染色カラーでも形や柄・濃淡などにかなり差があるためすべて一点ものになります。
他の組み合わせもございますので、是非ご覧ください◎
何か感じられた方、ヒーリングチャイムで癒されてみたいな~という方、是非お迎えしていただけましたら嬉しいです : )
――――――――――✶――――――――――
✧✧✧ご購入をお考えの方はこちらもお読みください✧✧✧
✶決済方法について
↓恐れ入りますがご協力のほどよろしくお願いいたします。
未払いによるキャンセルが多くなっており、
コンビニ決済と銀行振込につきましては、
決済の選択肢が他にない場合にのみお選びいただけますと大変助かります
(必ずご購入がお決まりの場合にのみ購入画面にお進みください)
事情があり期日内の入金が難しい場合はご連絡いただけましたら別途対応させていただきますので未払いによるキャンセルは避けていただきますよう、どうぞよろしくお願いいたします。
✶発送スケジュールについて
(火曜日までにお支払い確定分につきましては)その週の水曜日に発送予定となります
✶パッケージについて
通常で、ご自宅用・ギフト用関わらず画像のようなパッケージで発送させていただいております。
→可愛さのあるデザイン(LIGHT - NEON)と、スタイリッシュなデザイン(WATER - SILVER)の2種類ありますので、デザインのご希望ありましたら下記のプルダウンオプションよりご選択ください : )
※写真だとわかりづらいですがオーロラ色の部分は偏光色の箔ステッカーでいずれも同じものです。
※特にご指定なしの場合、最後の画像のような感じでリボン等アソートでさせていただいております。
✶ギフト用の場合
また、お包み方法は同じなのですが、お渡ししやすいよう、納品書等と分けて、商品だけを内袋で小分けにして梱包しておりますので、ギフト用の場合は下記のプルダウンオプションでご選択ください。
簡単なものにはなりますが中身の見える透明のお渡し袋を同梱させていただくこともできます。
・ギフト用(お渡し袋はなしでOK)
・ギフト用(お渡し袋を希望する)
→カートに入れる前に下部のプルダウンオプションでご選択ください